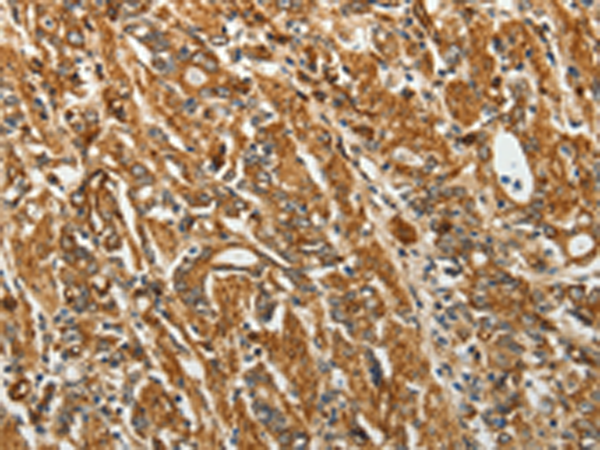

中文名稱(chēng):兔抗RPLP0多克隆抗體
英文名稱(chēng): Anti-RPLP0 rabbit polyclonal antibody
別 名: P0; LP0; L10E; RPP0; PRLP0
抗 原: RPLP0
儲(chǔ) 存: 冷凍(-20℃)
宿 主: Rabbit
相關(guān)類(lèi)別: 一抗
反應(yīng)種屬: Human, Mouse, Rat
標(biāo)記物: Unconjugate
克隆類(lèi)型: rabbit polyclonal
Background:
Ribosomes, the organelles that catalyze protein synthesis, consist of a small 40S subunit and a large 60S subunit. Together these subunits are composed of 4 RNA species and approximately 80 structurally distinct proteins. This gene encodes a ribosomal protein that is a component of the 60S subunit. The protein, which is the functional equivalent of the E. coli L10 ribosomal protein, belongs to the L10P family of ribosomal proteins. It is a neutral phosphoprotein with a C-terminal end that is nearly identical to the C-terminal ends of the acidic ribosomal phosphoproteins P1 and P2. The P0 protein can interact with P1 and P2 to form a pentameric complex consisting of P1 and P2 dimers, and a P0 monomer. The protein is located in the cytoplasm. Transcript variants derived from alternative splicing exist; they encode the same protein. As is typical for genes encoding ribosomal proteins, there are multiple processed pseudogenes of this gene dispersed through the genome.
Applications:
ELISA, WB, IHC
Name of antibody:
RPLP0
Immunogen:
Fusion protein of human RPLP0
Full name:
Ribosomal protein, large, P0
Synonyms:
P0; LP0; L10E; RPP0; PRLP0
SwissProt:
P05388
IHC positive control:
Human gastric cancer and human ovarian cancer
IHC Recommend dilution:
50-200
WB Predicted band size:
34 kDa
WB Positive control:
NIH/3T3, A431 and Jurkat cells
WB Recommended dilution:
500-2000
技術(shù)規(guī)格

購(gòu)物車(chē)
購(gòu)物車(chē) 幫助
幫助
 021-54845833/15800441009
021-54845833/15800441009
